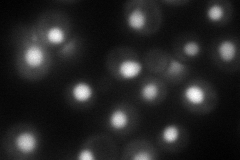
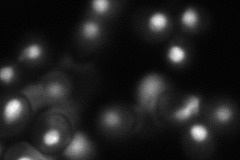
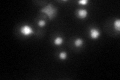

View description
TATA-binding protein, general transcription factor that interacts with other factors to form the preinitiation complex at promoters, essential for viability
Localization:
Intensity:
Fold change:
Significance:
-
C’ GFP library in SD

nucleus69.96 -
N' NOP1pr-GFP in SD

nucleus163.619 -
N' TEF2pr-mCherry in SD
nucleus105.745 -
N' NATIVEpr-GFP in SD
nucleus76.6443 -
N' TEF2pr-VC and Cyto-VN in SD

#N/A0 -
C’ GFP library in SD+DTT
nucleus53.10.75No -
C’ GFP library in SD+H2O2

nucleus52.450.74No -
C’ GFP library in Starvation Media

nucleus56.760.81No -
C’ GFP library on the background of Pup2-DaMP

nucleus -
C’ GFP library on the background of CCT mutant

nucleus65.92270.942189No
